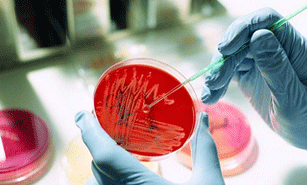

导致足癣的原因有哪些?
足癣是一种季节性疾病,多在夏季,患者而且平时不注意卫生的人更容易得足癣。得足癣后会出现强烈的痒症,严重影响患者的正常生活,而且足癣还能破坏皮肤的免疫功能,诱发多种疾病,需要及时治疗。那么足癣发病的常见原因有哪些?听听郑州肤康皮肤病专科医生的讲解。

1、合适的环境
温暖潮湿的环境适合足癣致病真菌生长繁殖,因此足癣多发病在夏季尤其是梅雨季节发病率高,也是南方比北方足癣发病率高的原因。密闭的鞋子能营造出温暖潮湿的环境,从而导致真菌大量繁殖,从而诱发足癣。
2、不良的卫生习惯
足癣多发病在生活习惯不良的人身上,如不注意卫生,长时间不更换鞋袜,不注意洗脚,这些习惯会导致鞋袜上堆积大量致病真菌,而这些致病真菌就是导致足癣的直接诱因,尤其是患者脚部受伤或者感冒发烧等免疫力下降时就容易得足癣。
3、传染诱发
足癣是一种真菌感染导致的皮肤病,有很强的传染性,日常生活中不注意护理的话,很容易就会因接触携致病真菌的物品而得足癣,如使用公共拖鞋、浴巾、公共修脚工具等行为都容易沾染致病真菌,导致足癣发病。
一、中西医药物结合抗真菌疗法 三大特色助力手足癣治疗
特色一:齐全仪器,准确判断。该疗法通过多功能齐全的的仪器检测,精确诊断病情,促进皮肤的新陈代谢,恢复皮肤正常功能,以免出现误诊。

特色二:结合外用药联合进行,一般外用为主,杀灭真菌非常快速,具有消炎、止痒、去臭、去湿,杀灭真菌的特殊功效。

特色三:改善皮肤微循环,良好抑制脚汗。可在短期迅速控制真菌的生长,快速从源上脚气反复发作。
温馨提示:健康是每个人都必须重视的。同时我院为了更好的服务患者,专科网站开设了皮肤病医生在线服务,是为了方便网友及时了解一些相关疾病知识,您可直接选择在线与我院医生进行及时沟通。医生会据您的病情提供专业治疗方案,并为您的隐私保密。关注身心健康、缔造健康人生!

郑州肤康皮肤病专科隶属上海交大附属专科临床教学专科、上海江城皮肤病专科临床协作单位。肤康引进上海交大和江城专科的医疗管理模式和诊疗机制,在医学技术、人才培养、科研创新等方面开展全方位合作,提升皮肤专科医疗水平。肤康由交大附属专科专家定期来院门诊、疑难复杂病例会诊和远程医疗门诊,让郑州市民能够就近享受到更高层次、更优质量的医疗卫生服务。
三、自助预约24小时便捷通道
郑州肤康皮肤病专科为方便郑州市民进行预约看诊,特开通24小时绿色预约通道,只要你拨打免费电话tel:037186635912直接拨打专家热线,就可以免费预约看诊,或者在线与专家对话、与专家在线看诊。在线预约>>>
手足癣病友都在问

- 郑州肤康皮肤病专科是通过卫生局批准成立的中医特色皮肤病专科连锁品牌。肤康以“中西医结合”的诊疗模式,专科、专病、专治皮肤病……【查看详情】





电话







